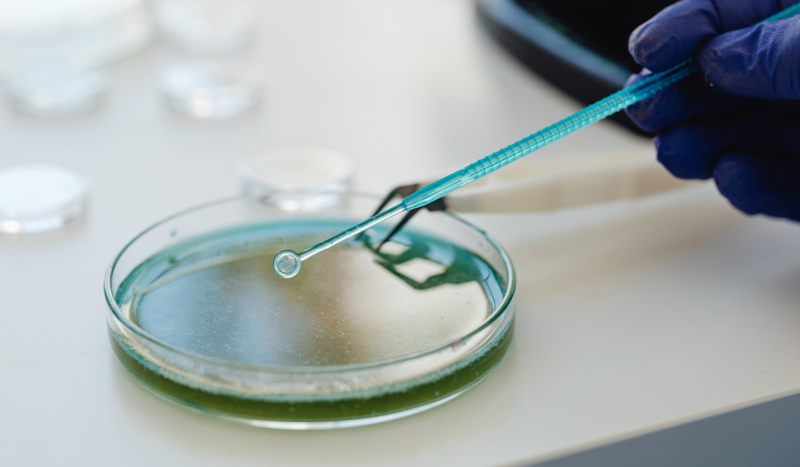

CV NEWS FEED // The Supreme Court of Alabama ruled Friday that frozen human embryos conceived via in vitro fertilization (IVF) are children, with human rights under state law.
In the court’s opinion, Justice Jay Mitchell cited the Wrongful Death of a Minor Act. He wrote that the state law “applies to all children, born and unborn, without limitation” and “regardless of their location.”
“It is not the role of this Court to craft a new limitation based on our own view of what is or is not wise public policy,” Mitchell stated.
“That is especially true where, as here, the People of this State have adopted a Constitutional amendment directly aimed at stopping courts from excluding ‘unborn life’ from legal protection,” he went on.
Mitchell referred to the Sanctity of Life Amendment, which was added to the Alabama constitution in 2018 after voters approved it by a wide margin.
The amendment states that Alabama “acknowledges, declares, and affirms that it is the public policy of this state to recognize and support the sanctity of unborn life and the rights of unborn children, including the right to life.”
“This state further acknowledges, declares, and affirms that it is the public policy of this state to ensure the protection of the rights of the unborn child in all manners and measures lawful and appropriate,” the amendment adds.
Chief Justice Tom Parker in a concurring opinion invoked both Holy Scripture and Judeo-Christian tradition on Friday.
“The theologically based view of the sanctity of life adopted by the People of Alabama encompasses the following,” Parker wrote:
God made every person in His image; each person therefore has a value that far exceeds the ability of human beings to calculate; and human life cannot be wrongfully destroyed without incurring the wrath of a holy God, who views the destruction of His image as an affront to Himself.
Justice Greg Cook was the only member of Alabama’s highest court to side against the majority. In his dissenting opinion, Cook remarked that the ruling “almost certainly ends the creation of frozen embryos through in vitro fertilization (‘IVF’) in Alabama.”
All nine justices of the Alabama Supreme Court are Republicans.
AL.com reported that as a result of the ruling, “[t]hree couples whose frozen embryos were destroyed when a wandering Mobile hospital patient dropped the specimens can sue for wrongful death.”
Per AL.com, the couples had accused the hospital and the fertility clinic where their embryos were conceived “of wrongful death, negligence and breach of contract in two lawsuits filed in 2021 in Mobile County Circuit Court.” The hospital and clinic argued that “Alabama’s Wrongful Death of a Minor Act does not cover embryos outside the womb.”
Mobile County Circuit Court Judge Jill Parrish Phillips sided with the hospital and clinic and dismissed the lawsuit in 2022. Phillips’ decision was reversed by Friday’s landmark state Supreme Court ruling.

